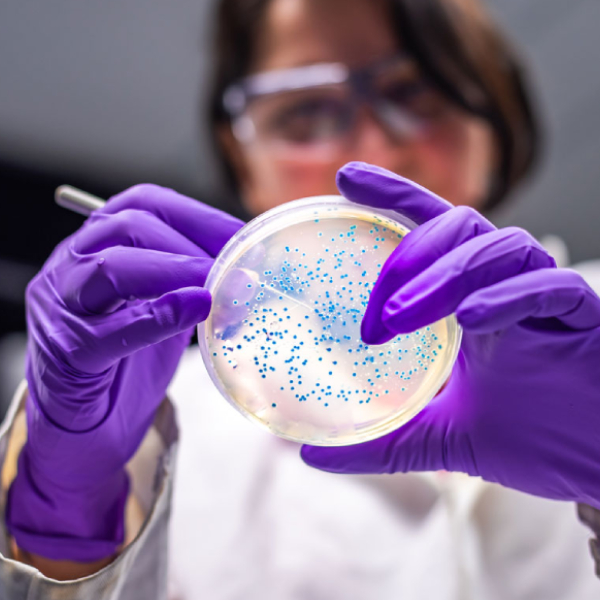

About Us

OmniBioPro is more than a solution provider—we’re your strategic partner in revolutionizing healthcare innovation. With decades of global experience, we specialize in bridging the gap between science and business, helping our partners overcome the complexities of modern healthcare challenges, from molecules to medicine and helping patients.
Our expertise encompasses all types of modalities from vaccine, therapeutic, and diagnostic, including biologics, CGT, ADCs, mRNA, oligo, small molecules, RPT, and advanced combinational products such as viral and non-viral delivery platforms.
From early discovery to post-market lifecycle management, OmniBioPro drives success through end-to-end solutions tailored to every stage of development. Additionally, we also specialize in corporate structuring, training programs, legal advisory, and operational streamlining to address client-specific needs comprehensively. All is transcribed by our OmniBioPro’s DNA of unwavering commitment to innovation, confidentiality, and client success. We have a unique blend of scientific excellence with business acumen, we ensure our clients thrive in a competitive, evolving healthcare ecosystem.

What We Do

At OmniBioPro, we specialize in bridging the gap between science and strategy to deliver tailored solutions for every stage of healthcare innovation. Whether it’s identifying promising candidates, optimizing processes, navigating regulatory landscapes, or driving commercialization, our expertise ensures your success.
Our Approach:
From discovery to commercialization, we provide end-to-end solutions that empower our clients to innovate, grow, and succeed in a competitive global market. Our collaborative approach ensures tailored strategies, integrating expertise in preclinical research, GMP manufacturing, market strategy development, regulatory compliance, and more.

What Sets Us Apart:

- Innovation: Embracing cutting-edge science to solve the toughest challenges.
- Collaboration: Building lasting partnerships through trust and transparency.
- Integrity: Upholding confidentiality, ethical practices, and excellence.
- Global Impact: Delivering solutions that improve lives worldwide.
Our Mission
To advance global healthcare by delivering innovative products, tailored solutions, expert guidance, and strategic insights. At OmniBioPro, we empower our partners to achieve technical excellence, streamline operations, and accelerate the journey from concept to market—all while upholding the highest standards of integrity, quality, and trust. Grounded in integrity, collaboration, and innovation, OmniBioPro delivers tailored solutions to drive transformative healthcare progress

Our Vision
To be a global leader in healthcare innovation, shaping the future of medicine through transformative solutions that have a lasting impact on global health.
